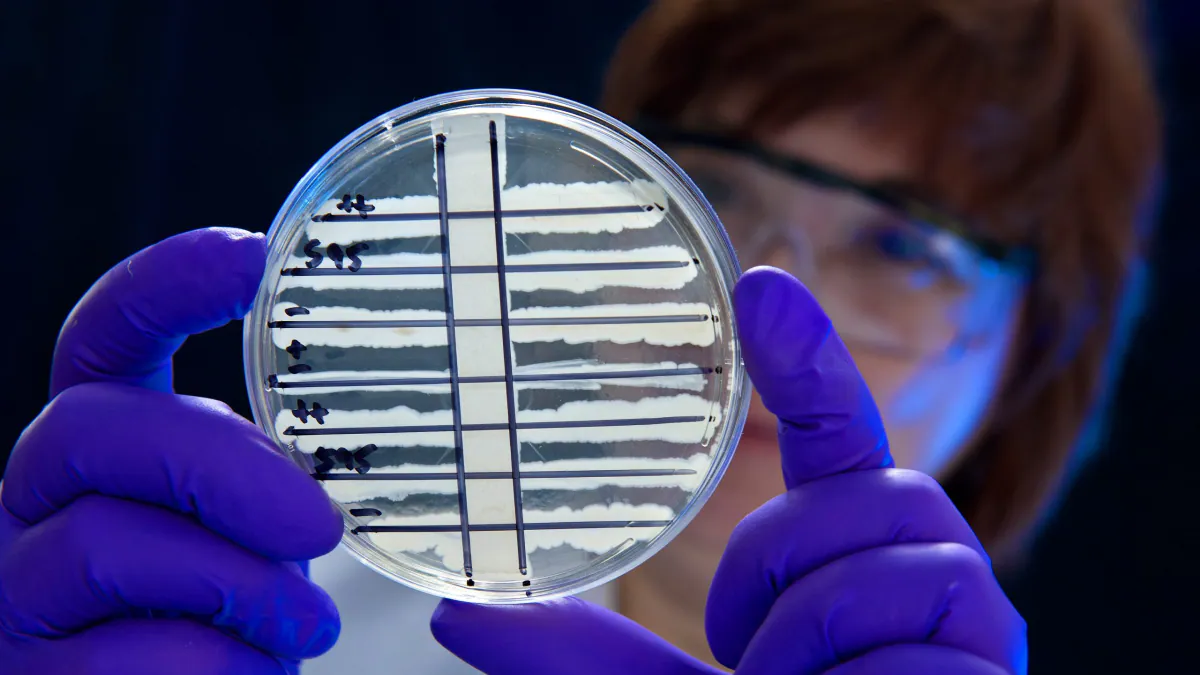
Corynebacterium diphtheriae on an Elek plate.

Key points
- Clinical laboratories can use various methods to identify Corynebacterium diphtheriae, but identification alone isn't enough for diagnosis confirmation.
- CDC uses culture and molecular methods, and a specialized toxin production test to confirm diphtheria diagnoses.
- Confirmatory testing informs clinical management and public health action to prevent further spread.
Overview
Laboratories must follow a series of steps in order to confirm a diphtheria diagnosis:
- Identifying and isolating C. diphtheriae
- Detecting the diphtheria toxin (tox) gene
- Showing toxin production
Confirmation of toxin production is key
Toxin-producing strains of C. diphtheriae cause diphtheria. Most U.S. strains that possess the tox gene don't express it or produce toxin. Therefore, tests that identify C. diphtheriae or detect the tox gene but don't confirm toxin production are insufficient to confirm a diphtheria diagnosis.
Lab methods
Culturing and identifying C. diphtheriae
Many clinical laboratories throughout the United States can conduct tests to isolate and identify C. diphtheriae.
Bacterial culture is used to isolate and help identify the bacteria. Colonies of gram-positive bacilli isolated on culture can then be further identified by additional tests. These tests include:
- Biochemical assays
- Matrix-assisted laser desorption/ionization-time of flight mass spectrometry (MALDI-TOF)
- Polymerase chain reaction (PCR)
Detecting the tox gene
If C. diphtheriae are isolated, the next step is to assess whether the bacteria possess the tox gene. Some state public health laboratories can conduct PCR testing for detection of the tox gene. However, in most parts of the United States, isolates must be sent to CDC for this testing.
Showing toxin production
Most C. diphtheriae in the United States that possess the tox gene don't actually express it, meaning they don't produce diphtheria toxin.
Confirmation of toxin production must be conducted via the Elek test. The Elek test is an in vitro immunoprecipitation (immunodiffusion) assay. Currently, CDC is the only laboratory in the United States that performs the Elek test.
Confirmatory testing also informs public health action
Specimen collection
Obtain specimens for bacterial culture from the suspected site of infection. Common specimen collection sites are
- The nares and oropharynx
- Any mucosal or cutaneous lesion
- Beneath the membrane or a portion of the membrane itself, if possible
Collect culture specimens prior to antibiotic treatment, if possible. Specimens are more likely to be culture-positive if obtained before the patient receives antibiotic treatment.
Specimen collection for diphtheria culture of the nose, throat, or wounds can be conducted using standard swab materials.
Submitting specimens
Specimen acceptance criteria
CDC only accepts various specimen types for C. diphtheriae testing from public health laboratories and other federal agencies.
Specimens from private healthcare providers and institutions must be submitted to a public health department laboratory for appropriate processing.
Specimen, documentation, packaging, and shipping
Specimen requirements vary by the specific test requested.
The following links provide information on specimen, documentation, packaging, and shipping requirements: